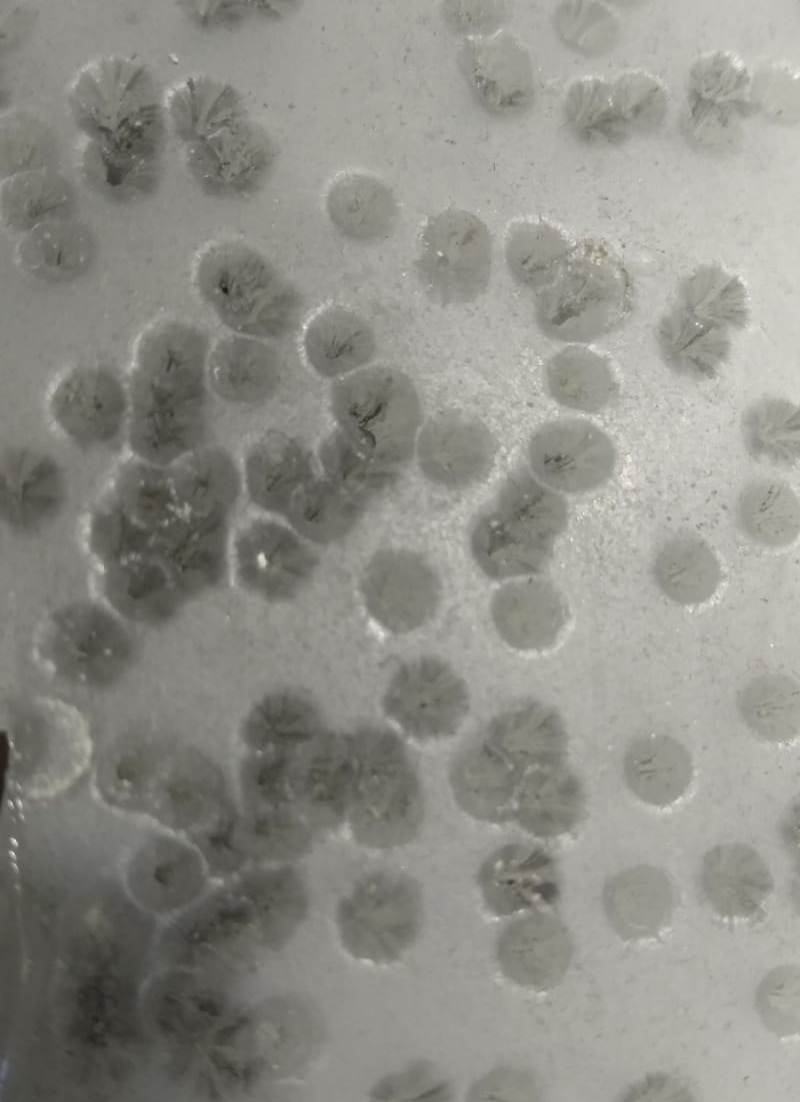

Poäng 10
Elektroniskt mål för 10m (gevär/pistol)
SETA SCORE 10 Elektroniskt mål för 10m DSB-discipliner.
Lämplig för privat eller tävlingsbruk. Tack vare de robusta och högkvalitativa komponenterna är systemet även lämpligt för låga och höga temperaturer eller hög luftfuktighet. • självförklarande yta • optimal träffvisning • zoomfunktion • touch-aktiverad • matchräknare, skotttiming • gratis uppdateringstjänst • DSB-program 10m lufttryck • detaljerad matchrapport • Windows 10-kompatibel • beprövad robust ultraljudsmätteknik • temperaturområde - 10 till 50°C • ingen imma • inget blydamm i rummet • stängd kulfälla • bevis på enskilda skott • service från tillverkaren • hölje av rostfritt stål VA • högkvalitativa komponenter • 5 års garanti • Tillverkad i Tyskland Leveransen omfattar en komplett System med väggfäste, USB-gränssnitt och mjukvara på USB-minne. Allt du behöver är en dator eller surfplatta med operativsystemet Windows 10
Poäng 10 Pro
Elektroniskt mål för 10m (gevär/pistol) & 50m (22lr.rifle)
de Score10 Pro
byggdes på basis av de beprövade Score10-systemen, systemet var utrustat med en förstärkt ytterdörr och en utbytbar kulfälla av gelgranulat Poäng 10 Cube
utrustade. Således kan systemet även användas för 50m små gevär. Särskilt mindre klubbar använder denna flexibilitet och använder systemen säsongsmässigt både på 10 m lufttrycksintervallet och på 50 m small bore gevärsbanan. Genom att helt enkelt byta kulfälla kan en konvertering utföras med bara några enkla steg. Score-10-Cube är en gelkulfångare som är fylld med granulat, vilket gör att inget blydamm bildas. Kulorna bromsas av gelplattan som stängs igen och fastnar i granulatet. Speciellt med äldre system är problemet med blydamm som uppstår när det träffar en stålplåt löst.
Poäng 25/50
Elektroniskt mål för 25m (pistol) & 50m (gevär/pistol)
de Poäng 25/50 Pro
byggdes på basis av de beprövade Score10-systemen. Systemet har utvecklats med internationellt erfarna skyttar. Systemet är även utrustat med en gelgranulat kulfälla 600x600mm. Systemet kan användas för 25m & 50m pistoldiscipliner samt för 50m fripistol och gevär med liten hål. Många klubbar drar nytta av systemets flexibilitet och använder systemen säsongsmässigt både på 25 m pistolbanan med trafikljuskontroll och på 50 m. Kulfällan är en gelkulfälla fylld med granulat vilket gör att det inte finns något bly. damm avfyras kulorna från gelplattan som stänger igen bromsade och fastnade i granulatet. Speciellt med äldre system är problemet med blydamm som uppstår när det träffar en stålplåt löst.
Poäng 25 RF (Rapid Fire)
Elektroniskt mål för 25m (pistol) & 50m (gevär/pistol)
de Poäng 25 RFutvecklades på basis av Score25/50-systemen. Systemet har utvecklats med internationellt erfarna skyttar och tränare. Systemet kan utrustas med en 5-faldig kulfälla med gelgranulat. Systemet ska användas för 25m pistolgrenar samt för olympiska snabbskjutspistoler. Kulfällan är en gelkulfälla som är fylld med granulat så det finns inget blydamm Kulorna bromsas av gelplattan som stängs igen och fastnar i granulatet. Blyet kan enkelt separeras från granulatet genom att helt enkelt sikta och sedan lägga tillbaka i uppsamlingslådan. Gelplattorna kan även återanvändas genom att smälta om dem.
gel kulfällor
Shootcube-serien består av gelplattor, granulat och kompletta kulfångssystem.
Dessa övertygar genom:
Inget ljud från stötande projektiler.
Gelkulfällan kan användas från -20°C till 55°C.
Slitna gelark och granulat är 100 % återanvändbara och helt återvinningsbara.
Ingen studs eller smuts i rummet eller på rutan.
Mycket hållbart (ca 30 000 varv före underhåll)
Mycket billig reparation.
Inget blydamm från stötande projektiler.
Projektilerna bromsas kraftigt i gelplattan, som är stängd av din
termiska egenskaper efter penetration.
Kulan bromsas helt ner i gummigranulatet bakom den och blir kvar där.
Granulat och projektiler kan separeras genom att helt enkelt sikta.
En ren separation är en barnlek, allt material som används kan återvinnas på ett hållbart sätt, så det finns inget avfall. Ytterligare information och priser här på hemsidan i prislistorna, dessa finns även som PDF under Nedladdningar.
Specialstorlekar finns också.